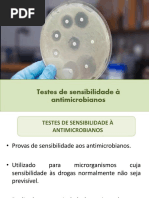

0% acharam este documento útil (0 voto)
37 visualizações2 páginasFolder twinsensorRT Cap-Lab
O documento apresenta um novo teste rápido para detecção simultânea de resíduos de antibióticos betalactâmicos e tetraciclinas em leite, com resultados em 10 minutos e sem necessidade de preparação da amostra. O teste é validado para diferentes tipos de leite e possui uma validade de 24 meses, além de ser fácil de usar tanto no campo quanto em laboratório. Inclui uma tabela de interpretação visual dos resultados e acessórios opcionais para leitura dos testes.
Enviado por
deborazambon096Direitos autorais
© © All Rights Reserved
Levamos muito a sério os direitos de conteúdo. Se você suspeita que este conteúdo é seu, reivindique-o aqui.
Formatos disponíveis
Baixe no formato PDF, TXT ou leia on-line no Scribd
0% acharam este documento útil (0 voto)
37 visualizações2 páginasFolder twinsensorRT Cap-Lab
O documento apresenta um novo teste rápido para detecção simultânea de resíduos de antibióticos betalactâmicos e tetraciclinas em leite, com resultados em 10 minutos e sem necessidade de preparação da amostra. O teste é validado para diferentes tipos de leite e possui uma validade de 24 meses, além de ser fácil de usar tanto no campo quanto em laboratório. Inclui uma tabela de interpretação visual dos resultados e acessórios opcionais para leitura dos testes.
Enviado por
deborazambon096Direitos autorais
© © All Rights Reserved
Levamos muito a sério os direitos de conteúdo. Se você suspeita que este conteúdo é seu, reivindique-o aqui.
Formatos disponíveis
Baixe no formato PDF, TXT ou leia on-line no Scribd